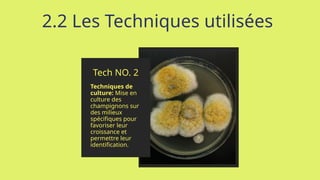
2.2 Les Techniques utilisées
Tech NO. 2
Techniques de
culture: Mise en
culture des
champignons sur
des milieux
spécifiques pour
favoriser leur
croissance et
permettre leur
identification.
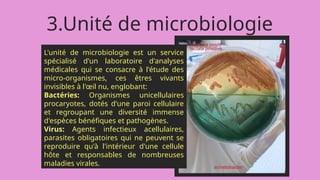
3.Unité de microbiologie
L'unité de microbiologie est un service
spécialisé d'un laboratoire d'analyses
médicales qui se consacre à l'étude des
micro-organismes, ces êtres vivants
invisibles à l'œil nu, englobant:
Bactéries: Organismes unicellulaires
procaryotes, dotés d'une paroi cellulaire
et regroupant une diversité immense
d'espèces bénéfiques et pathogènes.
Virus: Agents infectieux acellulaires,
parasites obligatoires qui ne peuvent se
reproduire qu'à l'intérieur d'une cellule
hôte et responsables de nombreuses
maladies virales.
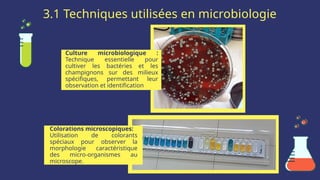
3.1 Techniques utilisées en microbiologie
Culture microbiologique :
Technique essentielle pour
cultiver les bactéries et les
champignons sur des milieux
spécifiques, permettant leur
observation et identification
Colorations microscopiques:
Utilisation de colorants
spéciaux pour observer la
morphologie caractéristique
des micro-organismes au
microscope.

L'organisation d'un laboratoire est essentielle pour optimiser les recherches et analyses menées, nécessitant une gestion efficace de l'espace, des ressources humaines et équipements, ainsi que des procédures de sécurité et de qualité. Diverses unités telles que la parasitologie, l'hormonologie et la microbiologie, chacune avec ses spécificités techniques, jouent un rôle clé dans l'analyse des échantillons biologiques pour des diagnostics précis. Un engagement envers l'amélioration continue est crucial pour s'adapter aux évolutions et garantir des résultats de qualité.